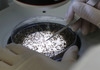

가을비가 내린 13일 오후 서울 용산역에서 우산을 쓴 시민들이 발걸음을 재촉하고 있다. 2024.9.13/뉴스1 ⓒ News1 장수영 기자 |
(서울=뉴스1) 김민수 기자 = 20일 금요일은 전국이 흐린 가운데 늦은 저녁까지 강한 비가 내리겠다.
기상청은 이날부터 모레(22일) 사이 돌풍과 함께 천둥·번개를 동반한 강한 비가 내리는 곳이 있겠다고 예보했다. 특히 이날 오전 수도권에 시간당 20~30㎜, 강원도·충청권·전라권·경상권·제주도엔 오후부터 30~50㎜의 비가 내리겠다.
20~22일 예상 강수량은 △수도권 30~100㎜(많은 곳 경기남부 150㎜ 이상, 서울·인천·경기북부 120㎜ 이상) △서해5도 30~80㎜ △강원동해안·산지 100~200㎜ (많은 곳 300㎜ 이상) △강원내륙 30~100㎜ (많은 곳 남부내륙 150㎜ 이상, 중.북부내륙 120㎜ 이상) △충청권 50~100㎜(많은 곳 150㎜ 이상) △전라권(많은 곳 남해안, 지리산부근, 전북북부 150㎜ 이상)이다.
같은 기간 △부산·울산·경남 50~120㎜ (많은 곳 부산·경남남해안 200㎜ 이상, 지리산부근 150㎜ 이상) △경북북부 50~120㎜ (많은 곳 북부동해안 180㎜ 이상, 북부내륙.북동산지 150㎜ 이상) △대구·경북남부·울릉도·독도 50~100㎜ (많은 곳 남부동해안 150㎜ 이상) △제주도(북부 제외) 50~150㎜ (많은 곳 산지 250㎜ 이상, 중산간 200㎜ 이상) △제주도북부 30~80㎜의 비가 예상된다.
낮 기온은 26~31도로 전날(26~37도)보다 2~3도가량 낮겠다. 다만 오늘 밤사이 전라서해안과 남해안, 제주도해안을 중심으로 열대야가 나타나는 곳이 있겠으니, 건강관리에 유의해야 한다.
지역별상세관측자료(AWS)에 따르면 이날 오전 6시 17분 기준 현재 주요 도시 기온은 △서울 25.5도 △인천 25.6도 △춘천 25.4도 △강릉 24.7도 △대전 26.2도 △대구 26.3도 △전주 27.2도 △광주 23.9도 △부산 28.3도 △제주 26.9도다.
최고 기온은 △서울 28도 △인천 28도 △춘천 26도 △강릉 27도 △대전 29도 △대구 29도 △전주 30도 △광주 29도 △부산 30도 △제주 32도로 예상된다.
제주도와 일부 전남해안에 강풍특보가 발효된 가운데, 이날까지 바람이 순간풍속 시속 70㎞ 이상(산지 110㎞ 이상)으로 매우 강하게 불겠으며, 일부 중부지방과 그 밖의 전남해안에도 바람이 순간풍속 시속 55㎞ 내외로 강하게 불겠다.
풍랑 특보가 발효된 남해서부먼바다와 서해남부남쪽먼바다, 제주도앞바다(제주도북부앞바다 제외)는 이날까지 바람이 시속 30~70㎞로 매우 강하게 불고 물결도 2~4m로 높게 일겠다. 제14호 태풍 풀라산의 발달 정도와 진로에 따라 예보가 변경될 가능성도 있어 최신 예보를 참고해야 한다.
미세먼지 농도는 전 권역이 '좋음'으로 예상된다.
kxmxs4104@news1.kr
Copyright ⓒ 뉴스1. All rights reserved. 무단 전재 및 재배포, AI학습 이용 금지.




![[시간들] 김범석과 유승준, 그대들에게 모국은 '옵션'이 아니다](/_next/image?url=https%3A%2F%2Fthumb.zumst.com%2F256x144%2Fhttps%3A%2F%2Fstatic.news.zumst.com%2Fimages%2F3%2F2025%2F12%2F24%2FAKR20251223059200546_01_i.jpg&w=384&q=100)